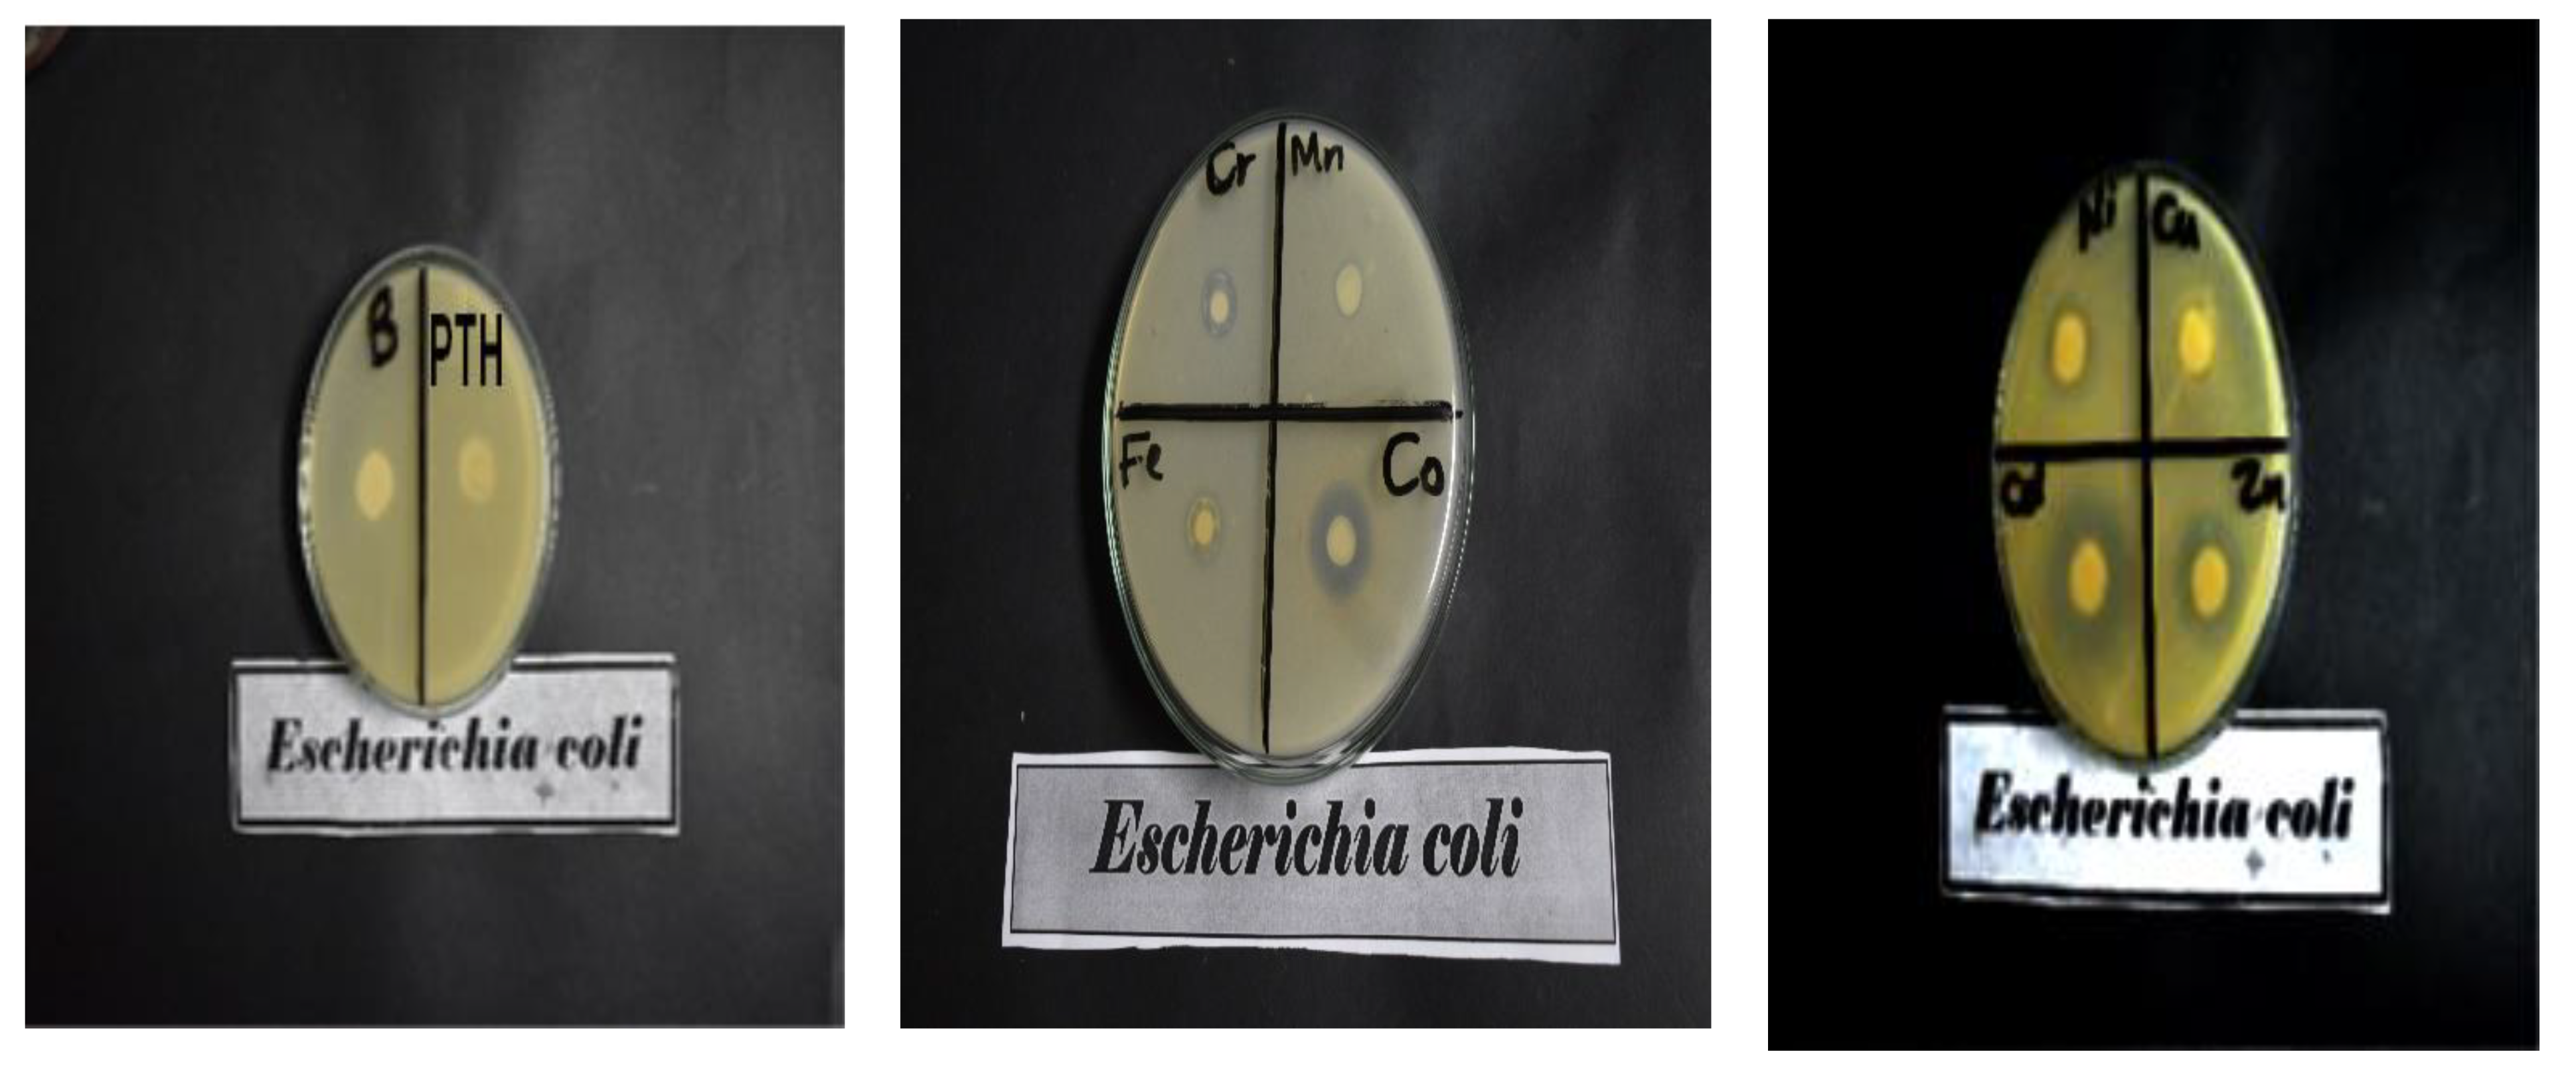
Inorganics 11 00231 g007
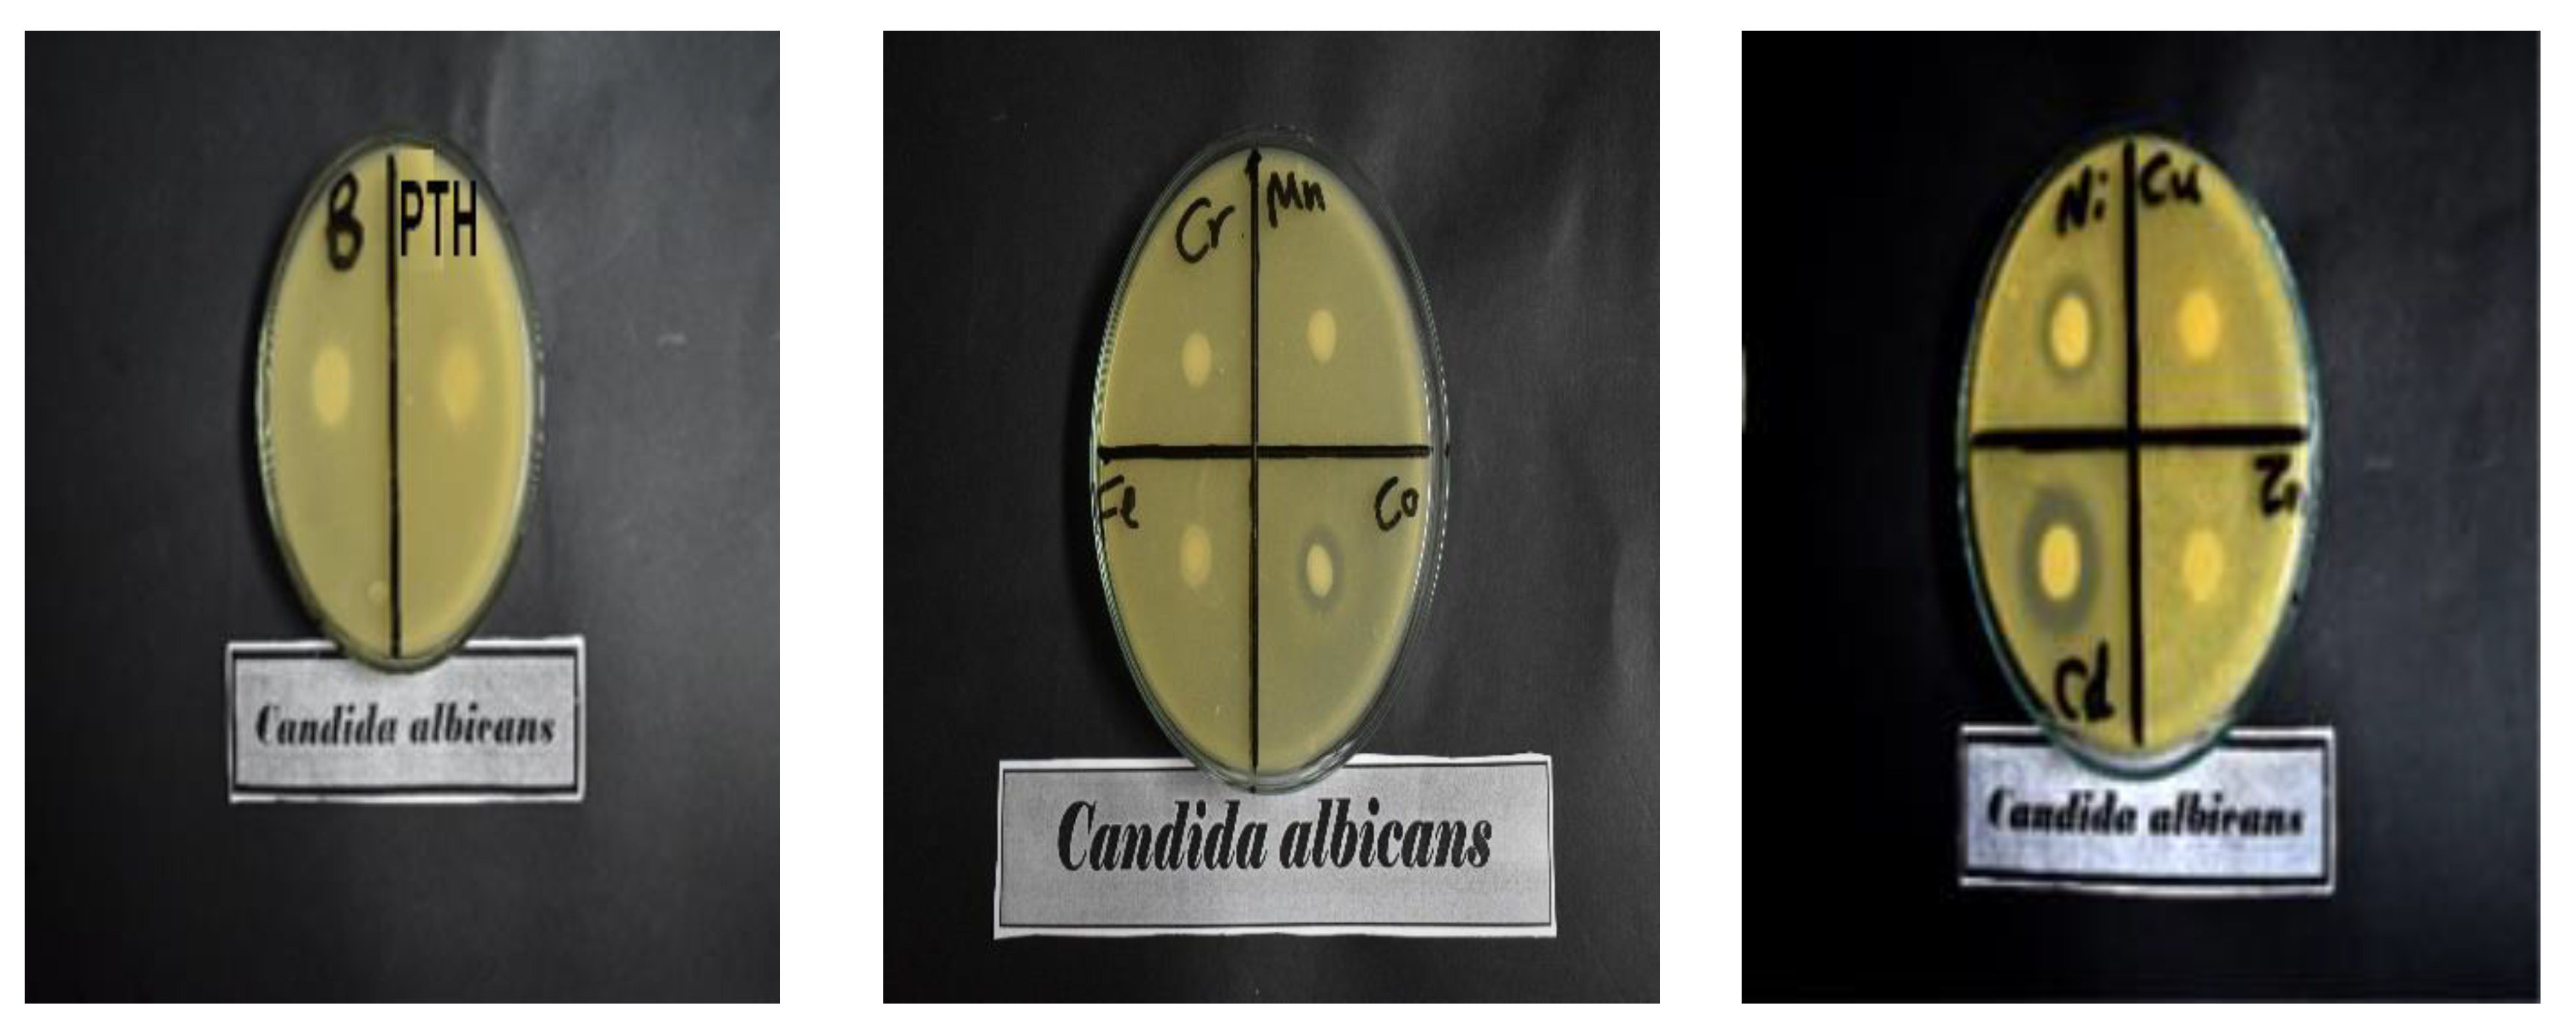
Inorganics 11 00231 g008

Novel Pyrimidinethione Hydrazide Divalent and Trivalent Metal Complexes for Improved High-Performance Antimicrobial and Durable UV Blocking Cellulosic Fabric
Abstract
1. Introduction
2. Results and Discussions
2.1. Mechanism of Coating Cotton Fabric
2.2. FTIR Analysis
2.3. XRD Analysis
2.4. SEM/EDX Analysis
2.5. Antimicrobial Activity
2.6. UV Protection
2.7. The Add-On (%) Loading and Tensile Strength
3. Materials and Methods
3.1. Materials
3.2. Chemicals
3.3. Methods
3.3.1. Preparation of the Ligand
3.3.2. Coating of Cotton Fabric with Metal–Ligand Complexes
3.4. Instruments
3.5. Antimicrobial Test Method
3.6. Tensile Strength
3.7. The Add-On (%) Loading
3.8. Ultraviolet Protection Factor (UPF)
3.9. Statistical Analysis
4. Conclusions
Author Contributions
Funding
Data Availability Statement
Acknowledgments
Conflicts of Interest
References
- Kobenan, K.C.; Bini, K.K.N.; Kouakou, M.; Kouadio, I.S.; Zengin, G.; Ochou, G.E.C.; Boka, N.R.K.; Menozzi, P.; Ochou, O.G.; Dick, A.E. Chemical Composition and Spectrum of Insecticidal Activity of the Essential Oils of Ocimum gratissimum L. and Cymbopogon citratus Stapf on the Main Insects of the Cotton Entomofauna in Côte d’Ivoire. Chem. Biodivers. 2021, 18, e2100497. [Google Scholar] [CrossRef] [PubMed]
- Li, Z.-F.; Zhang, C.-J.; Cui, L.; Zhu, P.; Yan, C.; Liu, Y. Fire retardant and thermal degradation properties of cotton fabrics based on APTES and sodium phytate through layer-by-layer assembly. J. Anal. Appl. Pyrolysis 2017, 123, 216–223. [Google Scholar] [CrossRef]
- Hsieh, Y.-L. Chemical structure and properties of cotton. In Cotton: Science and Technology; Woodhead Publishing: Sawston, UK, 2007; pp. 3–34. [Google Scholar]
- Mirjalili, M.; Yaghmaei, N.; Mirjalili, M. Antibacterial properties of nano silver finish cellulose fabric. J. Nanostructure Chem. 2013, 3, 1–5. [Google Scholar] [CrossRef]
- Burniston, N.; Bygott, C.; Stratton, J. Nano technoology meets titanium dioxide. Surf. Coat. Int. Part A Coat. J. 2004, 87, 179–184. [Google Scholar]
- Gómez, E.M.P.; Silva, O.F.; Der Ohannesian, M.; Fernández, M.N.; Oliveira, R.G.; Fernández, M.A. Micelle-to-vesicle transition of lipoamino Gemini surfactant induced by metallic salts and its effects on antibacterial activity. J. Mol. Liq. 2022, 353, 118793. [Google Scholar] [CrossRef]
- Liu, Y.; Ma, K.; Li, R.; Ren, X.; Huang, T. Antibacterial cotton treated with N-halamine and quaternary ammonium salt. Cellulose 2013, 20, 3123–3130. [Google Scholar] [CrossRef]
- Osman, E.M.; Khalil, A.A.; El-Shrbini, M.H.; Reda, L.M.; Shaaban, A.F. Characterization and evaluation of phosphorus/nitrogen-containing polymer as a durable flame retardant for cotton fabrics. J Appl Chem Sci Int 2015, 3, 39–52. [Google Scholar]
- Alihosseini, F. Plant-based compounds for antimicrobial textiles. In Antimicrobial Textiles; Elsevier: Amsterdam, The Netherlands, 2016; pp. 155–195. [Google Scholar]
- Eid, B.M.; El-Sayed, G.M.; Ibrahim, H.M.; Habib, N.H. Durable antibacterial functionality of cotton/polyester blended fabrics using antibiotic/MONPs composite. Fibers Polym. 2019, 20, 2297–2309. [Google Scholar] [CrossRef]
- Elnaggar, M.; Emam, H.; Fathalla, M.; Abdel-Aziz, M.; Zahran, M. Chemical synthesis of silver nanoparticles in its solid state: Highly efficient antimicrobial cotton fabrics for wound healing properties. Egypt. J. Chem. 2021, 64, 2697–2709. [Google Scholar] [CrossRef]
- El-Sayed, S.S.; Alhakimi, A.N. Synthesis, characterization of Lanthanum mixed ligand complexes based on benzimidazole derivative and the effect of the added ligand on the antimicrobial, and anticancer activities. J. Qassim Univ. Sci. 2022, 15, 35–53. [Google Scholar]
- Gulati, R.; Sharma, S.; Sharma, R.K. Antimicrobial textile: Recent developments and functional perspective. Polym. Bull. 2022, 79, 5747–5771. [Google Scholar] [CrossRef] [PubMed]
- Staneva, D.; Atanasova, D.; Nenova, A.; Vasileva-Tonkova, E.; Grabchev, I. Cotton fabric modified with a PAMAM dendrimer with encapsulated copper nanoparticles: Antimicrobial activity. Materials 2021, 14, 7832. [Google Scholar] [CrossRef] [PubMed]
- Tausif, M.; Jabbar, A.; Naeem, M.S.; Basit, A.; Ahmad, F.; Cassidy, T. Cotton in the new millennium: Advances, economics, perceptions and problems. Text. Prog. 2018, 50, 1–66. [Google Scholar] [CrossRef]
- Čuk, N.; Šala, M.; Gorjanc, M. Development of antibacterial and UV protective cotton fabrics using plant food waste and alien invasive plant extracts as reducing agents for the in-situ synthesis of silver nanoparticles. Cellulose 2021, 28, 3215–3233. [Google Scholar] [CrossRef]
- Alebeid, O.K.; Zhao, T. Review on: Developing UV protection for cotton fabric. J. Text. Inst. 2017, 108, 2027–2039. [Google Scholar] [CrossRef]
- Lee, S. Developing UV-protective textiles based on electrospun zinc oxide nanocomposite fibers. Fibers Polym. 2009, 10, 295–301. [Google Scholar] [CrossRef]
- Abidi, N.; Hequet, E.; Tarimala, S.; Dai, L.L. Cotton fabric surface modification for improved UV radiation protection using sol–gel process. J. Appl. Polym. Sci. 2007, 104, 111–117. [Google Scholar] [CrossRef]
- Emam, H.E.; El-Shahat, M.; Hasanin, M.S.; Ahmed, H.B. Potential military cotton textiles composed of carbon quantum dots clustered from 4–(2, 4–dichlorophenyl)–6–oxo–2–thioxohexahydropyrimidine–5–carbonitrile. Cellulose 2021, 28, 9991–10011. [Google Scholar] [CrossRef]
- Emam, H.E.; El-Shahat, M.; Hasanin, M.S.; Ahmed, H.B. Potential Military Cotton Textiles by Carbon Quantum Dots. Cellulose 2021. [Google Scholar] [CrossRef]
- Dong, X.; Xing, T.; Chen, G. Durable antipilling modification of cotton fabric with chloropyrimidine compounds. Polymers 2019, 11, 1697. [Google Scholar] [CrossRef]
- Hu, Q.; Wang, W.; Ma, T.; Zhang, C.; Kuang, J.; Wang, R. Anti-UV and hydrophobic dual-functional coating fabrication for flame retardant polyester fabrics by surface-initiated PET RAFT technique. Eur. Polym. J. 2022, 173, 111275. [Google Scholar] [CrossRef]
- Karami, K.; Jamshidian, N.; Zakariazadeh, M.; Momtazi-Borojeni, A.A.; Abdollahi, E.; Amirghofran, Z.; Shahpiri, A.; Nasab, A.K. Experimental and theoretical studies of Palladium-hydrazide complexes’ interaction with DNA and BSA, in vitro cytotoxicity activity and plasmid cleavage ability. Comput. Biol. Chem. 2021, 91, 107435. [Google Scholar] [CrossRef] [PubMed]
- Alhakimi, A.N.; Shakdofa, M.M.; Saeed, S.; Shakdofa, A.M.; Al-Fakeh, M.S.; Abdu, A.M.; Alhagri, I.A. Transition Metal Complexes Derived from 2-hydroxy-4-(p-tolyldiazenyl) benzylidene)-2-(p-tolylamino) acetohydrazide Synthesis, Structural Characterization, and Biological Activities. J. Korean Chem. Soc. 2021, 65, 93–105. [Google Scholar]
- Katouah, H.A.; Al-Fahemi, J.H.; Elghalban, M.G.; Saad, F.A.; Althagafi, I.A.; El-Metwaly, N.M.; Khedr, A.M. Synthesis of new Cu (II)-benzohydrazide nanometer complexes, spectral, modeling, CT-DNA binding with potential anti-inflammatory and anti-allergic theoretical features. Mater. Sci. Eng. C 2019, 96, 740–756. [Google Scholar] [CrossRef] [PubMed]
- Alkhamis, K.; Alkhatib, F.; Alsoliemy, A.; Alrefaei, A.F.; Katouah, H.A.; Osman, H.E.; Mersal, G.A.; Zaky, R.; El-Metwaly, N.M. Elucidation for coordination features of hydrazide ligand under influence of variable anions in bivalent transition metal salts; green synthesis, biological activity confirmed by in-silico approaches. J. Mol. Struct. 2021, 1238, 130410. [Google Scholar] [CrossRef]
- Saeed, S.; Alomari, B.A.; Alhakimi, A.N.; El-Hady, A.; Alnawmasi, J.S.; Elganzory, H.H.; El-Sayed, W.A. Pyrimidine hydrazide ligand and its metal complexes: Synthesis, characterization, and antimicrobial activities. Egypt. J. Chem. 2022. [Google Scholar] [CrossRef]
- Abd El-Hady, M.; Sharaf, S.; Farouk, A. Highly hydrophobic and UV protective properties of cotton fabric using layer by layer self-assembly technique. Cellulose 2020, 27, 1099–1110. [Google Scholar] [CrossRef]
- Al-Hakimi, A.N.; Alminderej, F.; Aroua, L.; Alhag, S.K.; Alfaifi, M.Y.; Mahyoub, J.A.; Elbehairi, S.E.I.; Alnafisah, A.S. Design, synthesis, characterization of zirconium (IV), cadmium (II) and iron (III) complexes derived from Schiff base 2-aminomethylbenzimidazole, 2-hydroxynaphtadehyde and evaluation of their biological activity. Arab. J. Chem. 2020, 13, 7378–7389. [Google Scholar] [CrossRef]
- Büyükkidan, B.; Büyükkidan, N.; Aslı, A. New schiff bases derived from 3, 4-diamino-1h-1, 2, 4-triazole-5 (4h)-thione: Synthesis and characterization. J. Sci. Rep.-A 2022, 2687, 25–41. [Google Scholar]
- Kafle, K.; Greeson, K.; Lee, C.; Kim, S.H. Cellulose polymorphs and physical properties of cotton fabrics processed with commercial textile mills for mercerization and liquid ammonia treatments. Text. Res. J. 2014, 84, 1692–1699. [Google Scholar] [CrossRef]
- Ahmad, I.; Kan, C.-w.; Yao, Z. Photoactive cotton fabric for UV protection and self-cleaning. RSC Adv. 2019, 9, 18106–18114. [Google Scholar] [CrossRef] [PubMed]
- Lee, M.-J.; Kwon, J.-S.; Jiang, H.B.; Choi, E.H.; Park, G.; Kim, K.-M. The antibacterial effect of non-thermal atmospheric pressure plasma treatment of titanium surfaces according to the bacterial wall structure. Sci. Rep. 2019, 9, 1938. [Google Scholar] [CrossRef] [PubMed]
- El-Sayed Saeed, S.; Al-Harbi, T.M.; Abdel-Mottaleb, M.S.; Al-Hakimi, A.N.; Albadria, A.E.; Abd El-Hady, M.M. Novel Schiff base transition metal complexes for imparting UV protecting and antibacterial cellulose fabric: Experimental and computational investigations. Appl. Organomet. Chem. 2022, 36, e6889. [Google Scholar] [CrossRef]
- Al-Amiery, A.A.; Al-Majedy, Y.K.; Ibrahim, H.H.; Al-Tamimi, A.A. Antioxidant, antimicrobial, and theoretical studies of the thiosemicarbazone derivative Schiff base 2-(2-imino-1-methylimidazolidin-4-ylidene) hydrazinecarbothioamide (IMHC). Org. Med. Chem. Lett. 2012, 2, 4. [Google Scholar] [CrossRef] [PubMed]
- El-Afify, M.E.; Elsayed, S.A.; Shalaby, T.I.; Toson, E.A.; El-Hendawy, A.M. Synthesis, characterization, DNA binding/cleavage, cytotoxic, apoptotic, and antibacterial activities of V (IV), Mo (VI), and Ru (II) complexes containing a bioactive ONS-donor chelating agent. Appl. Organomet. Chem. 2021, 35, e6082. [Google Scholar] [CrossRef]
- Saeed, S.E.-S.; Al-Harbi, T.M.; Alhakimi, A.N.; Abd El-Hady, M. Synthesis and Characterization of Metal Complexes Based on Aniline Derivative Schiff Base for Antimicrobial Applications and UV Protection of a Modified Cotton Fabric. Coatings 2022, 12, 1181. [Google Scholar] [CrossRef]
- Tawiah, B.; Yu, B.; Yang, W.; Yuen, R.K.; Fei, B. Facile flame retardant finishing of cotton fabric with hydrated sodium metaborate. Cellulose 2019, 26, 4629–4640. [Google Scholar] [CrossRef]
- Sahito, I.A.; Sun, K.C.; Arbab, A.A.; Qadir, M.B.; Jeong, S.H. Integrating high electrical conductivity and photocatalytic activity in cotton fabric by cationizing for enriched coating of negatively charged graphene oxide. Carbohydr. Polym. 2015, 130, 299–306. [Google Scholar] [CrossRef]

| Inhibition Zone Diameter (mm/cm Sample) | ||||
|---|---|---|---|---|
| Treated Sample | Fungal Species | Bacterial Species | ||
| Candida albicans | Aspergillus flavus | Escherichia coli(G−) | Staphylococcus aureus (G+) | |
| Blank cotton fabric | 0 | 0 | 0 | 0 |
| PTH-C | 0 | 0 | 0 | 0 |
| Cr-PTH-C | 0 | 0 | 12 ± 0.24 | 12 ± 0.23 |
| Mn-PTH-C | 0 | 0 | 11 ± 0.3 | 12 ± 0.26 |
| Fe-PTH-C | 0 | 0 | 13 ± 0.31 | 16 ± 0.13 |
| Co-PTH-C | 16 | 0 | 17 ± 0.22 | 25 ± 0.4 |
| Ni-PTH-C | 22 | 0 | 14 ± 0.37 | 22 ± 0.42 |
| Cu-PTH-C | 0 | 0 | 16 ± 0.32 | 15 ± 0.28 |
| Zn-PTH-C | 0 | 0 | 20 ± 0.29 | 21 ± 0.33 |
| Cd-PTH-C | 27 | 33 | 18 ± 0.25 | 31 ± 0.5 |
| Sample Name | UPF | UV Transmittance | UPF after 10 Washing Cycles | |
|---|---|---|---|---|
| UV-A | UV-B | |||
| Blank cotton fabric | 5.4 ± 0.20 | 25.1 | 17.1 | 4.2 ± 0.42 |
| PTH-C | 41.4 ± 0.10 | 10.4 | 1.9 | 37.3 ± 0.18 |
| Cr-PTH-C | 55.0 ± 0.50 | 8.1 | 1.4 | 48.4 ± 0.32 |
| Mn-PTH-C | 47.1 ± 0.20 | 8 | 1.7 | 44.5 ± 0.22 |
| Fe-PTH-C | 113.3 ± 0.25 | 1.2 | 0.9 | 105.2 ± 0.3 |
| Co-PTH-C | 68.2 ± 0.20 | 6.8 | 1.1 | 61.5 ± 0.40 |
| Ni-PTH-C | 65.5 ± 0.30 | 8.3 | 1.1 | 57.2 ± 0.35 |
| Cu-PTH-C | 59.9 ± 0.34 | 2.6 | 1.5 | 56.1 ± 0.27 |
| Zn-PTH-C | 39 ± 0.15 | 10 | 2.1 | 33.7 ± 0.32 |
| Cd-PTH-C | 50.6 ± 0.18 | 9.4 | 1.5 | 46.6 ± 0.40 |
| Treatment | Add-On (%) | Tensile Strength (kg f) |
|---|---|---|
| Blank cotton fabric | -- | 54.7 ± 0.25 |
| PTH-C | 1.58 ± 0.1 | 51.8 ± 0.23 |
| Cr-PTH-C | 2.93 ± 0.2 | 49 ± 0.12 |
| Mn-PTH-C | 3.61 ± 0.4 | 47.2 ± 0.2 |
| Fe-PTH-C | 4.04 ± 0.06 | 48.5 ± 0.41 |
| Co-PTH-C | 4.22 ± 0.7 | 48.2 ± 0.45 |
| Ni-PTH-C | 3.4 ± 0.05 | 48.7 ± 0.3 |
| Cu-PTH-C | 4.30 ± 0.04 | 49.8 ± 0.15 |
| Zn-PTH-C | 1.87 ± 0.02 | 50.7 ± 0.37 |
| Cd-PTH-C | 4.25 ± 0.3 | 48.9 ± 0.11 |
Disclaimer/Publisher’s Note: The statements, opinions and data contained in all publications are solely those of the individual author(s) and contributor(s) and not of MDPI and/or the editor(s). MDPI and/or the editor(s) disclaim responsibility for any injury to people or property resulting from any ideas, methods, instructions or products referred to in the content. |
© 2023 by the authors. Licensee MDPI, Basel, Switzerland. This article is an open access article distributed under the terms and conditions of the Creative Commons Attribution (CC BY) license (https://creativecommons.org/licenses/by/4.0/).
Share and Cite
Saeed, S.E.-S.; Alomari, B.A.; Abd El-Hady, M.M.; Al-Hakimi, A.N. Novel Pyrimidinethione Hydrazide Divalent and Trivalent Metal Complexes for Improved High-Performance Antimicrobial and Durable UV Blocking Cellulosic Fabric. Inorganics 2023, 11, 231. https://doi.org/10.3390/inorganics11060231
Saeed SE-S, Alomari BA, Abd El-Hady MM, Al-Hakimi AN. Novel Pyrimidinethione Hydrazide Divalent and Trivalent Metal Complexes for Improved High-Performance Antimicrobial and Durable UV Blocking Cellulosic Fabric. Inorganics. 2023; 11(6):231. https://doi.org/10.3390/inorganics11060231
Chicago/Turabian StyleSaeed, Saeed El-Sayed, Budoor A. Alomari, Marwa. M. Abd El-Hady, and Ahmed N. Al-Hakimi. 2023. "Novel Pyrimidinethione Hydrazide Divalent and Trivalent Metal Complexes for Improved High-Performance Antimicrobial and Durable UV Blocking Cellulosic Fabric" Inorganics 11, no. 6: 231. https://doi.org/10.3390/inorganics11060231
APA StyleSaeed, S. E.-S., Alomari, B. A., Abd El-Hady, M. M., & Al-Hakimi, A. N. (2023). Novel Pyrimidinethione Hydrazide Divalent and Trivalent Metal Complexes for Improved High-Performance Antimicrobial and Durable UV Blocking Cellulosic Fabric. Inorganics, 11(6), 231. https://doi.org/10.3390/inorganics11060231

